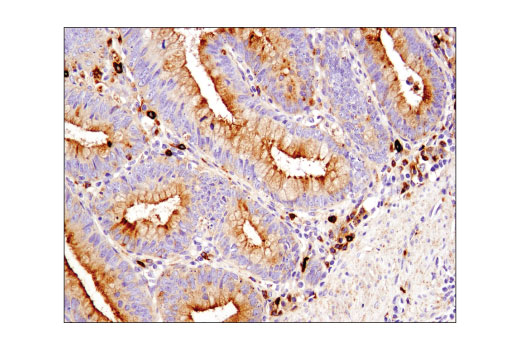
CD63 (D4I1X) Rabbit mAb (IHC Specific)

CD63 (D4I1X) Rabbit mAb (IHC Specific)
目录号:55051S
计量单位:PC
商品规格:100ul
分享商品:
无规格
这是用户近期浏览商品预览.
只要用户查看过一个商品这个片断就会显示.
只要用户查看过一个商品这个片断就会显示.